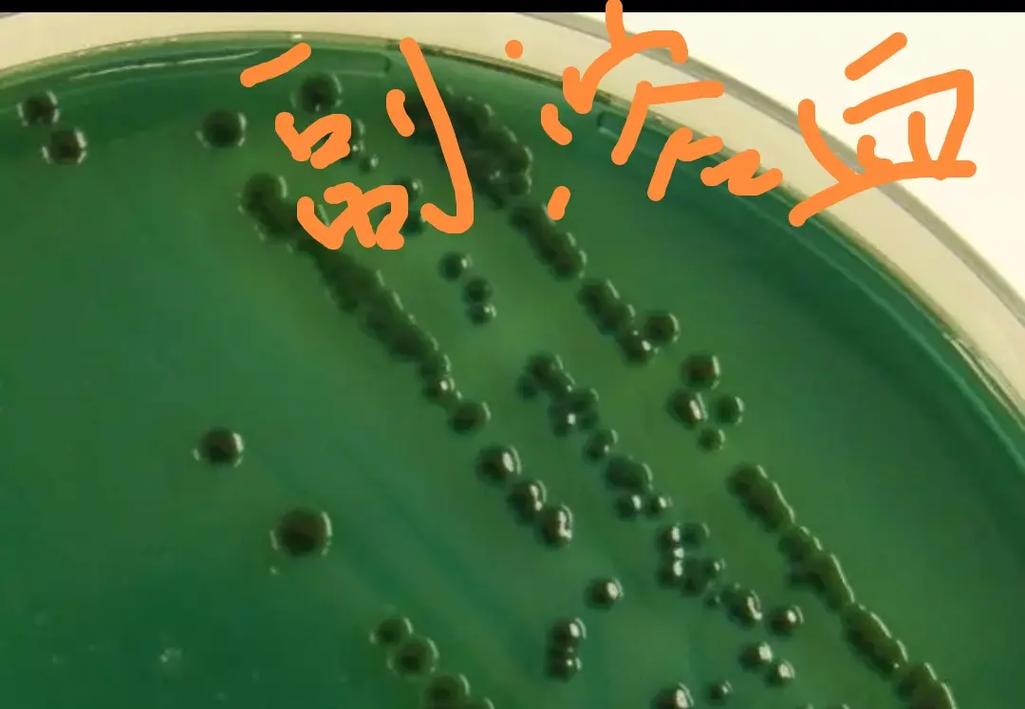
水产如何快速精准检测荧光弧菌？-第1张图片-宁夏农业信息网
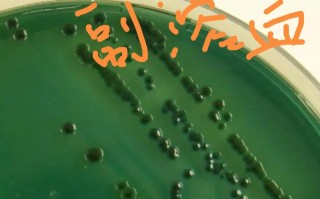
水产如何快速精准检测荧光弧菌？

检测前的准备工作
-
样品采集与保存:
- 代表性采样:从不同批次、不同部位(如肠道、鳃、肌肉)采集样品,确保样品具有代表性。
- 无菌操作:使用无菌工具(如无菌剪刀、镊子、采样袋)进行采样,避免交叉污染。
- 低温保存:样品采集后应立即置于4°C以下的保温箱中,并尽快送至实验室(最好在6小时内),若不能立即检测,应于-20°C或以下冷冻保存。
-
实验室安全:
(图片来源网络,侵删)
(图片来源网络,侵删)- 荧光弧菌,特别是副溶血性弧菌,属于生物安全二级(BSL-2)病原体,所有操作必须在生物安全柜中进行,操作人员需穿戴适当的个人防护装备(PPE),如实验服、手套、护目镜等。
检测方法详解
检测方法主要分为三大类:传统培养法、免疫学方法和分子生物学方法。
传统培养法(金标准,国标方法)
这是最经典、最可靠的方法,也是许多国家标准(如中国GB 4789.7-2025)规定的方法,它通过分离培养和生化鉴定来确定目标菌的存在。
步骤:
-
增菌:
 (图片来源网络,侵删)
(图片来源网络,侵删)- 目的:让目标菌(荧光弧菌)在混合菌群中大量繁殖,达到可检测的数量。
- 培养基:通常使用碱性蛋白胨水。
- 操作:将样品(如25g均质后的鱼体组织)加入到225ml的碱性蛋白胨水中,于37°C培养8-18小时。
-
分离:
- 目的:从增菌液中分离出单个的荧光弧菌菌落。
- 培养基:使用TCBS琼脂(Thiosulfate-Citrate-Bile-Sucrose Agar)或弧菌显色培养基。
- TCBS琼脂:荧光弧菌(副溶血性弧菌)在此培养基上会发酵蔗糖,产生黄色菌落,其产生的硫化物会使菌落中心变黑,形成典型的“绿色带黑心”或黄色带黑心的菌落。
- 弧菌显色培养基:根据不同的酶底物,菌落会呈现不同颜色,特异性更高,便于识别,副溶血性弧菌可能呈现特定颜色(如蓝色)。
- 操作:用接种环蘸取增菌液,在TCBS平板上划线,37°C培养18-24小时。
-
生化鉴定:
- 目的:对分离到的可疑菌落进行确证。
- 操作:挑取TCBS上的可疑菌落,接种到一系列生化反应管中,关键鉴定项目包括:
- 氧化酶试验:荧光弧菌为阳性(菌落滴加氧化酶试剂后变紫/黑)。
- 革兰氏染色:为阴性(呈红色杆状)。
- 嗜盐性试验:在含3%、7%、10% NaCl的蛋白胨水中生长,但在不含NaCl或含10%以上NaCl的培养基中不生长。
- 其他生化反应:如葡萄糖发酵、靛基质试验、赖氨酸脱羧酶试验等。
-
毒力基因检测(可选但重要):
- 目的:并非所有副溶血性弧菌都致病,致病菌株携带特定的毒力基因,如
tdh(耐热直接溶血素基因)和trh(TDH相关溶血素基因)。 - 方法:对生化鉴定为阳性的菌株,使用PCR方法检测
tdh和trh基因,只有携带这些基因的菌株才被认为是致病性菌株。
- 目的:并非所有副溶血性弧菌都致病,致病菌株携带特定的毒力基因,如
优点:

(图片来源网络,侵删)
- 可获得活的菌株,便于后续研究(如药敏试验、溯源)。
- 成本相对较低,不需要昂贵的大型设备。
- 是仲裁和标准检测的“金标准”。
缺点:
- 耗时长,通常需要3-5天。
- 操作繁琐,对人员技术要求高。
- 灵敏度相对较低,当菌量少时容易漏检。
免疫学方法
这类方法利用抗原和抗体的特异性结合来检测,速度快,适合现场或初步筛查。
-
酶联免疫吸附试验:
- 原理:将抗体包被在酶标板上,加入样品后,若样品中有目标菌抗原,就会与抗体结合,再加入酶标二抗和底物,会产生颜色反应,通过测定吸光度值来判断是否存在目标菌。
- 应用:主要用于检测增菌后的样品,提高灵敏度,市面上已有针对副溶血性弧菌的商业ELISA检测试剂盒。
- 优点:通量高,可以同时检测多个样品。
- 缺点:可能存在交叉反应(与其他弧菌反应),灵敏度通常低于PCR,且只能检测到抗原,无法区分活菌和死菌。
-
胶体金免疫层析试纸条:
- 原理:类似于早孕试纸,将特异性抗体固定在硝酸纤维素膜的检测线上,胶体金标记的抗体固定在结合垫上,样品滴加后,若含有目标菌,会形成“抗体-抗原-金标抗体”复合物,并迁移到检测线处显色。
- 应用:现场快速检测,一些商业化的快速检测试纸条可以直接检测样品或增菌液,10-30分钟内出结果。
- 优点:速度极快,操作简单,无需专业仪器,适合企业和基层监管部门的快速筛查。
- 缺点:灵敏度较低,易受样品基质干扰,假阳性和假阴性率相对较高。
分子生物学方法
这类方法直接检测细菌的遗传物质(DNA),具有极高的特异性和灵敏度。
-
聚合酶链式反应:
- 原理:针对荧光弧菌(特别是副溶血性弧菌)的特异性基因序列(如
gyrB、toxR或毒力基因tdh、trh)设计引物,通过DNA扩增技术,将目标片段指数级放大,再通过凝胶电泳或实时荧光检测来判断结果。 - 操作:
- DNA提取:从样品或增菌液中提取细菌总DNA。
- PCR扩增:加入引物、酶、dNPTs等进行扩增。
- 结果检测:
- 普通PCR:扩增产物通过琼脂糖凝胶电泳,观察是否有目的条带。
- 实时荧光定量PCR:在反应体系中加入荧光探针,每完成一次DNA复制就会释放一个荧光信号,通过荧光信号的强度实时监测扩增过程,可对初始模板进行精确定量。
- 优点:
- 灵敏度高:可检测到极低数量的细菌(甚至单个细菌)。
- 特异性强:引物设计精准,不易交叉污染。
- 速度快:从DNA提取到结果通常只需2-4小时。
- 可定量:qPCR能精确估算样品中的细菌数量。
- 缺点:
- 仪器和试剂成本高。
- 容易发生PCR污染导致假阳性。
- 只能检测DNA,无法区分活菌和死菌(可通过联合使用RNA检测或活菌培养来解决)。
- 原理:针对荧光弧菌(特别是副溶血性弧菌)的特异性基因序列(如
-
环介导等温扩增技术:
- 原理:一种新型的恒温核酸扩增技术,利用一种具有链置换活性的Bst DNA聚合酶和特设计的引物,在恒温(通常为60-65°C)条件下,高效、快速地扩增DNA。
- 应用:非常适合现场快速检测,可以通过肉眼观察浑浊度、添加荧光染料(如SYBR Green)或使用便携式检测设备来判断结果。
- 优点:速度快(30-60分钟),设备简单(只需恒温水浴锅或便携式加热器),灵敏度高,抗干扰能力强。
- 缺点:引物设计比PCR更复杂,容易出现假阳性。
各方法对比与选择建议
| 方法类型 | 检测目标 | 优点 | 缺点 | 适用场景 |
|---|---|---|---|---|
| 传统培养法 | 活菌 | 金标准,获得活菌株,成本低 | 耗时长(3-5天),操作繁琐 | 法定检测、仲裁、实验室常规检测、溯源研究 |
| 免疫学方法 | 抗原 | 快速(分钟级),操作简单,现场适用 | 灵敏度较低,可能交叉反应,无法区分活死菌 | 企业自检、市场快速抽检、初步筛查 |
| 分子生物学方法 | DNA/RNA | 高灵敏度,高特异性,速度快(2-4小时) | 仪器和试剂成本高,易污染,无法区分活死菌 | 实验室确证、暴发疫情溯源、高灵敏度要求检测 |
总结与建议
- 常规监控与出厂检验:对于水产企业,可采用“增菌 + 快速试纸条/ELISA”的模式进行日常监控,快速发现问题,对于需要正式报告的,则必须使用传统培养法。
- 疫情暴发与溯源调查:当发生疑似荧光弧菌引起的食源性疾病时,应首选实时荧光PCR或qPCR方法,因为它能快速、准确地从患者样本或食品中检出病原体,并定量,对分离到的菌株进行毒力基因检测和分子分型(如PFGE、WGS),以追踪传染源。
- 科研与深度分析:需要进行菌株特性研究、耐药性分析或基因组学研究时,传统培养法是必不可少的,因为它能提供活的、纯的菌株。
在实际应用中,常常会将多种方法结合使用,例如先用PCR进行快速筛查,阳性样品再用传统方法分离菌株,从而兼顾效率、准确性和后续研究的可能性。
版权声明:除非特别标注,否则均为本站原创文章,转载时请以链接形式注明文章出处。